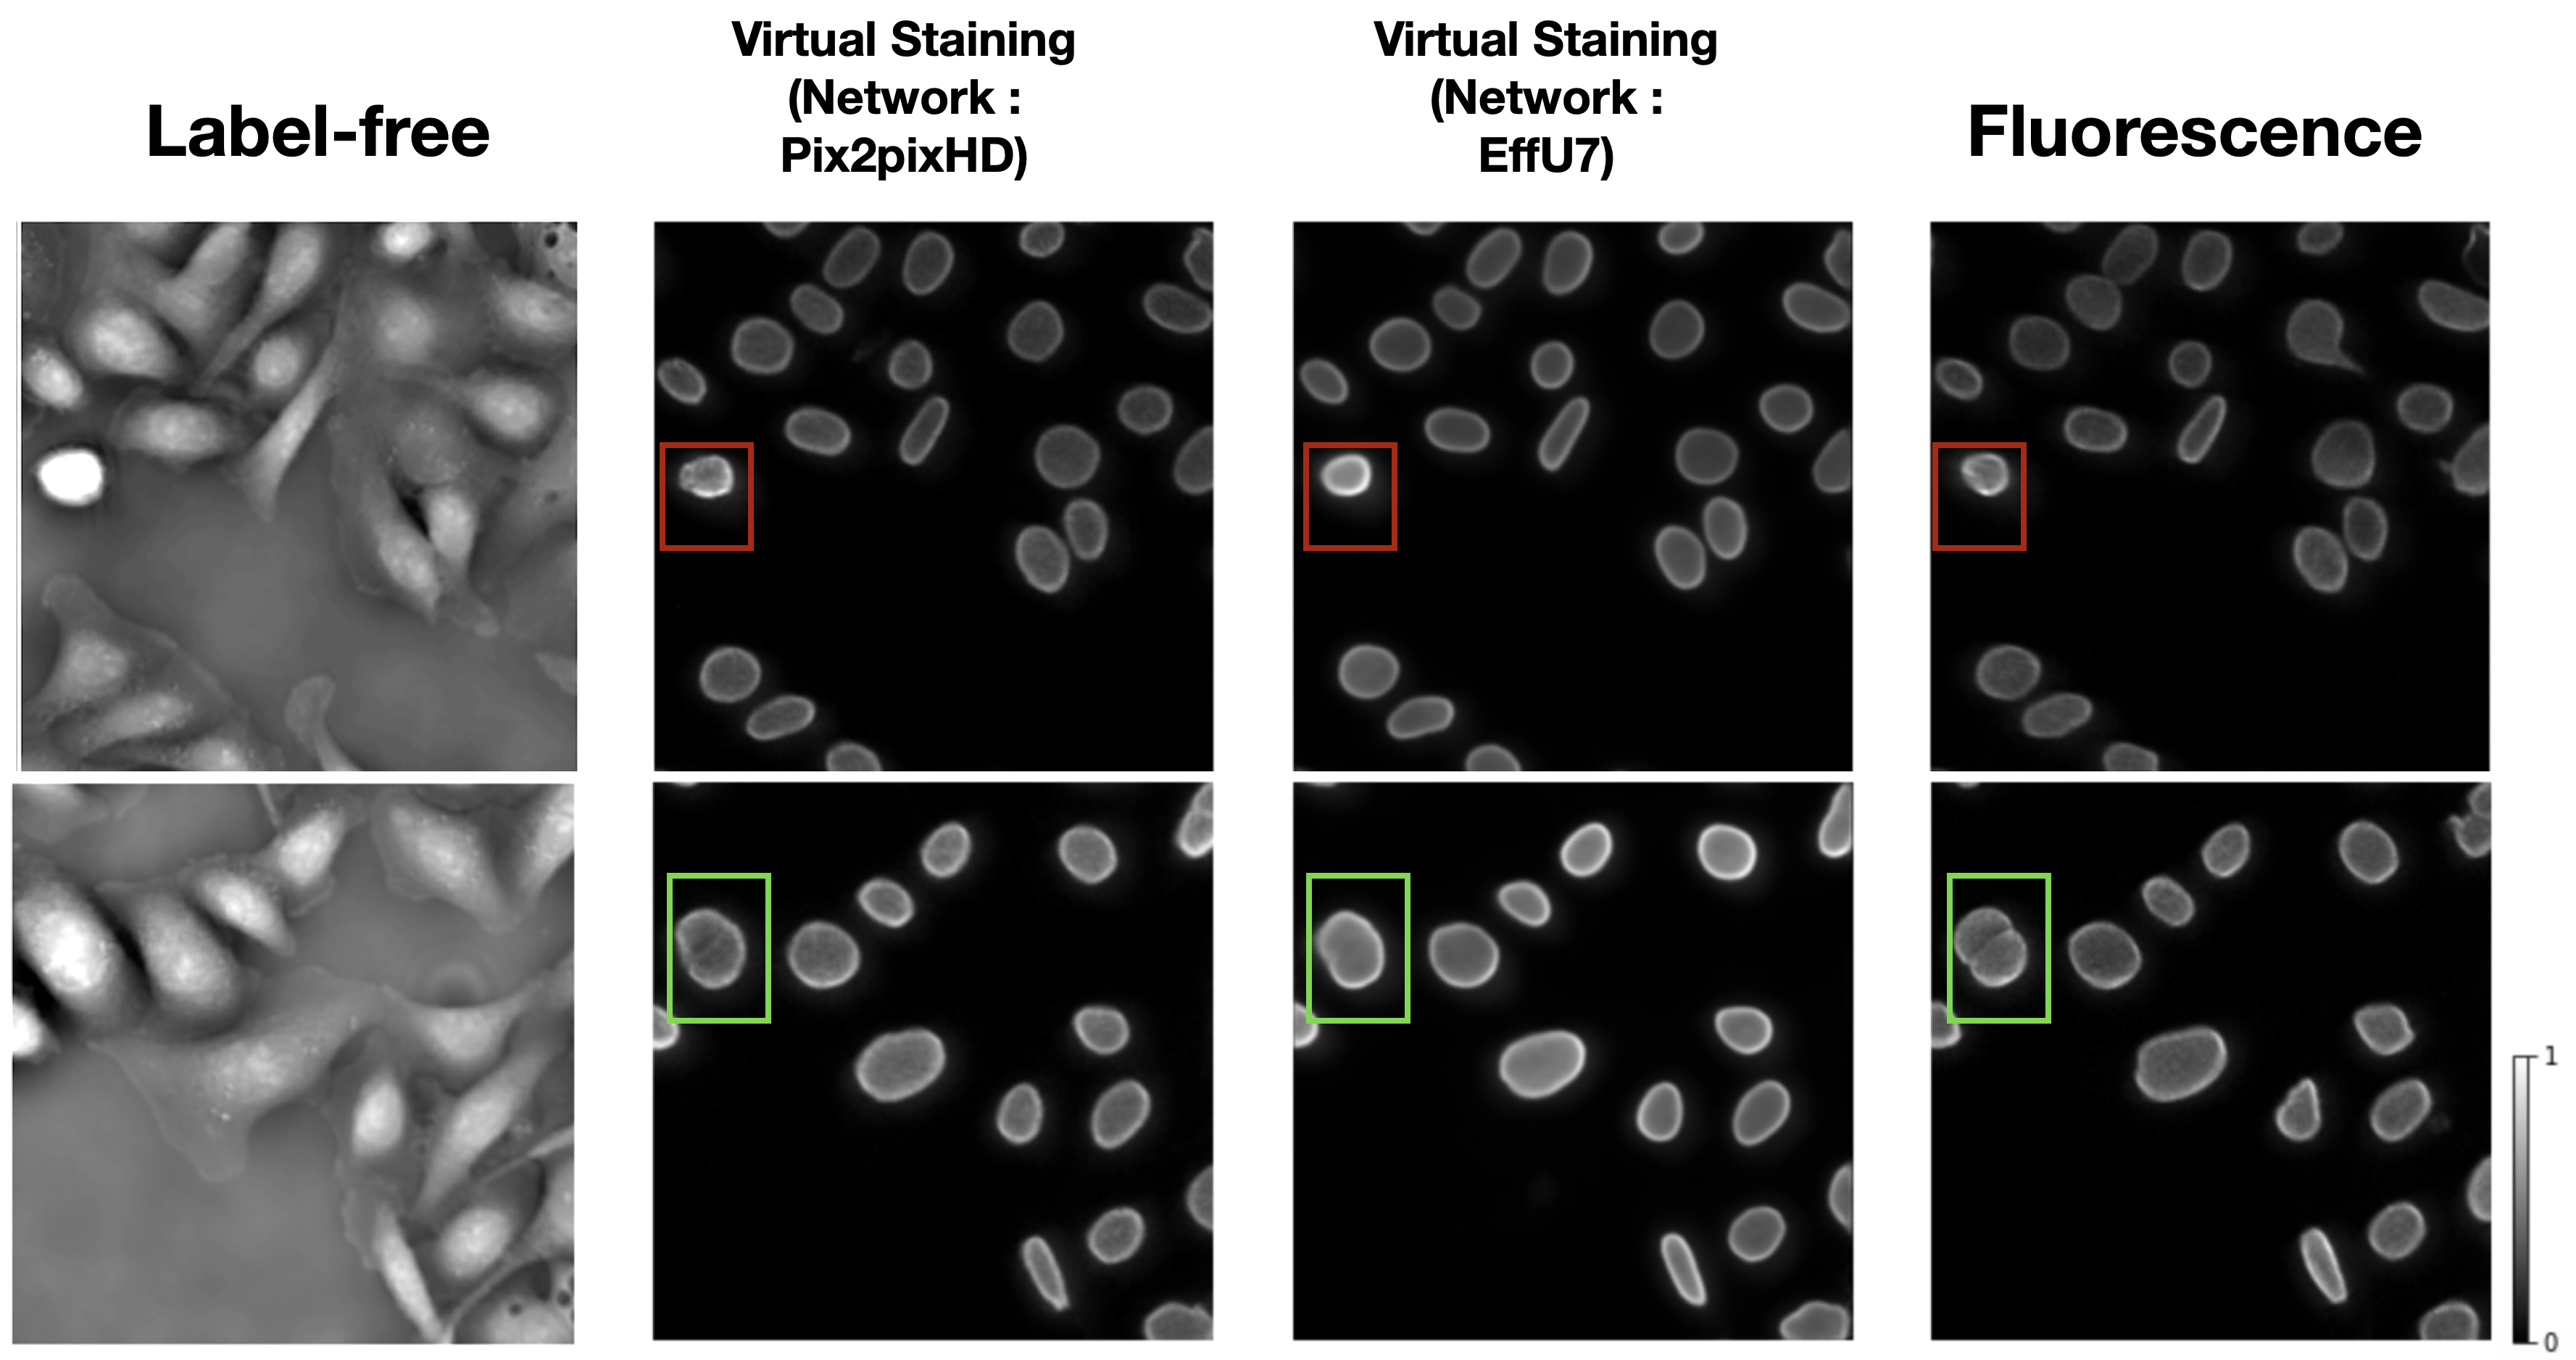
Utility of virtual staining and task network capacity

Research
For the complete publication list, please visit my Google Scholar
1) Generalizable & Large-Scale Foundation Models for Medical Image Segmentation
Building more generalizable and large-scale segmentation tools for different medical image segmentation tasks. Part of this is with the collaboration with GE Healthcare.
Relevant papers



2) Interpretable Deep Learning for Medical Imaging
Designing self-interpretable models and theory-grounded attribution based on statistical decision theory for medical image classification tasks.
Relevant papers



3) Information Theory for Objective Medical Image Quality Assessmenr
How does any medical image processing algorithm affect information in medical images? How does it affect any downstream clinical or biological tasks? Is a medical image processing algorithm always helpful in improving downstream task performance?
Relevant papers